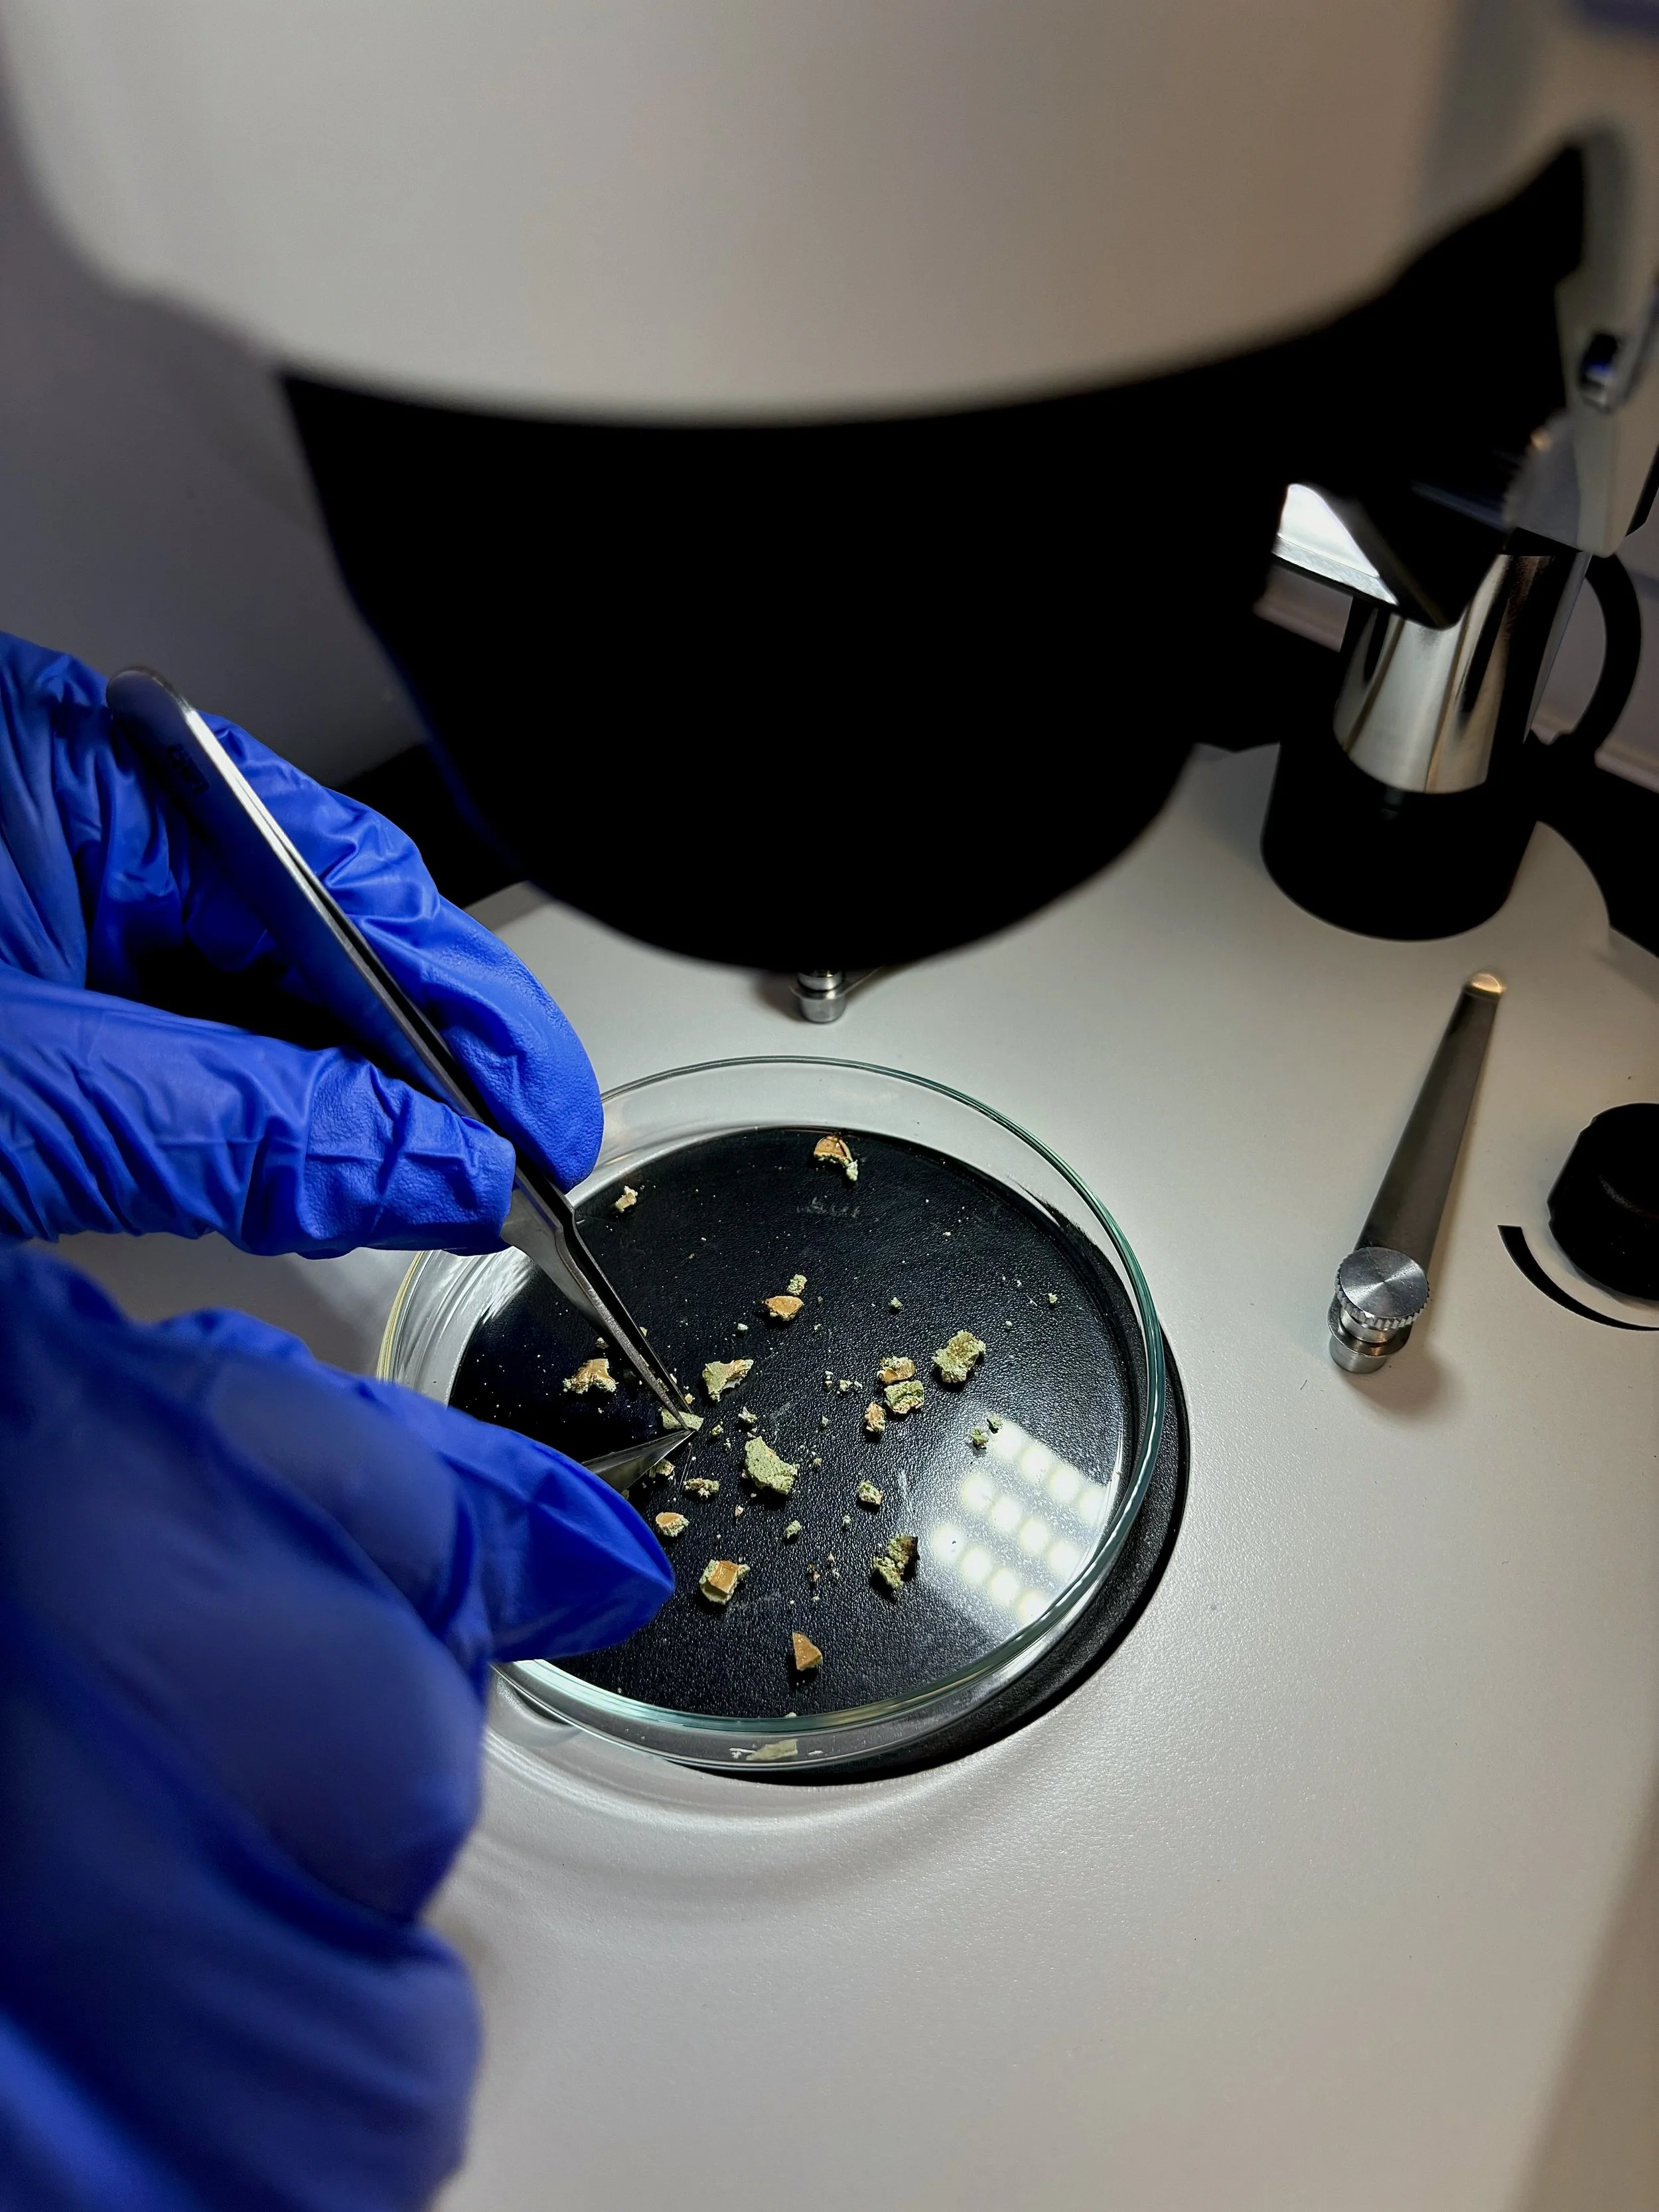

Asbestos Services

Full Sampling & Testing Services
At Asbestest, we deliver what others can’t. Instant, onsite asbestos testing with our fully equipped mobile laboratory. We bring expert analysis directly to your site, providing fast, accurate, and compliant results without the delays of offsite testing.
Perfect for construction, demolition, or emergency response, our service helps you make safe decisions quickly, eliminating sample transport and project downtime.
Our Process
1) Consult and Planning
We work closely with you to understand your project, site, and requirements so we can deliver the right solution.

2) Propety Inspection
We conduct a thorough property inspection to identify potential asbestos-containing materials and assess risk areas. This preparation ensures sampling and testing are targeted, safe, and efficient.

3) Sampling & Testing
Our team conducts safe, compliant sampling onsite, following strict internal procedures. Samples are then analysed immediately in our fully equipped mobile laboratory.


4) Same-Day Reporting
We provide clear and extensive same-day reports to support informed and confident decisions.

At Asbestest, we are actively working towards NATA accreditation. In addition, we are proudly certified for ISO 9001 Quality Management System, ISO 45001 OHS Management System, and ISO 14001 Environmental Management System. Both ISO Certification and NATA Accreditation demonstrates our commitment to quality, technical competence, and industry best practice. These important steps reflect our dedication to delivering reliable, accurate, and compliant asbestos testing services to our clients.
Achieving NATA accreditation will formally recognise the integrity of our methods, the strength of our quality system, and the expertise of our team, ensuring our mobile laboratory continues to set a new standard in the field.
Accreditation & Certification

